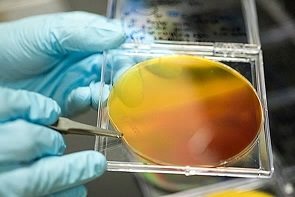

Science is getting closer to sun-powered cars
13 Mar 2017
![]() |

Air NZ inks deal for its first internationally verified carbon credits
Thu 9 Oct 2025
By Liz Kivi | Air New Zealand has committed to buying 8000 tonnes of carbon removals by 2030, in partnership with local native forest investment platform My Native Forest.

Kaikōura sets vision for non-carbon transport future
30 Sep 2025
By David Hill, Local Democracy Reporter | A new strategy is set to ‘‘transform’’ Kaikōura’s trails network.

KiwiRail unveils carbon reduction plan
25 Sep 2025
KiwiRail has released its first carbon reduction plan with a target of reducing emissions by 40% in the next decade and to reach net-zero carbon by 2050.

NZ needs to be part of a regional SAF strategy: Z, Air NZ
9 Sep 2025
By Pattrick Smellie | New Zealand needs to be part of a regional strategic approach to sourcing sustainable aviation fuel (SAF), with domestic production less the aim than ensuring access to the fuel from one of a number of strategically positioned bio-refineries around the world.

Air NZ declares surprisingly low SAF prices
3 Sep 2025
By Pattrick Smellie | Air New Zealand is able to source sustainable aviation fuel at between 1.5 and 2.5 times the price of conventional fossil fuels used for flying, all sourced from the US.

Fund for low emissions transport winds up
31 Jul 2025
New Zealand’s Low Emission Transport Fund has officially wrapped up, ending a nine-year programme that put hundreds of millions of dollars towards accelerating the country’s shift to cleaner transport.

EV sales fall, but it’s complicated
29 Jul 2025
Imports of fully electric vehicles fell over 50% in value during the 12 months to June 2025, compared with the year ended June 2024, according to Stats NZ.

Can robot taxis solve NZ's transport woes?
23 Jul 2025
By Shannon Morris-Williams | The Ministry of Transport has tested the idea of driverless taxis as a futuristic fix. But while new modelling explores how "robotaxis" could ease congestion and reduce car ownership, critics say it misses a crucial point – the country’s worsening transport emissions.

How flying can be a climate solution
16 Jun 2025
By Paul Callister and Robert McLachlan - Planetary Ecology | How can aviation contribute to tackling climate change when no practicable technology-based solutions are on the horizon?

“It’s not the car – it’s how we move” – EECA
3 Jun 2025
By Shannon Morris-Williams| New Zealand’s transport emissions conversation has focused heavily on electric vehicles – but Richard Briggs, group manager, delivery and partnerships at the Energy Efficiency and Conservation Authority, says we’re asking the wrong question.